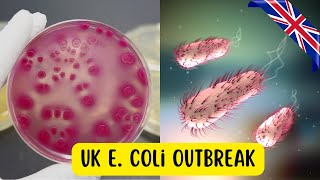

Welcome to our YouTube channel dedicated to helping you achieve your health and fitness goals! We believe that living a healthy lifestyle shouldn't be complicated or stressful. Our mission is to provide you with easy-to-follow and practical tips, workouts, and nutrition advice that will help you feel your best.
So, if you're ready to start your health and fitness journey, hit the subscribe button and join our community of like-minded individuals who are committed to living their healthiest and happiest lives. Let's get started!
Shared 1 year ago
237 views
Shared 1 year ago
28 views
Shared 1 year ago
54 views
Shared 1 year ago
13 views
Shared 1 year ago
5 views
Shared 1 year ago
24 views
Shared 1 year ago
18 views
Shared 2 years ago
23 views
Shared 2 years ago
7 views
Shared 2 years ago
22 views